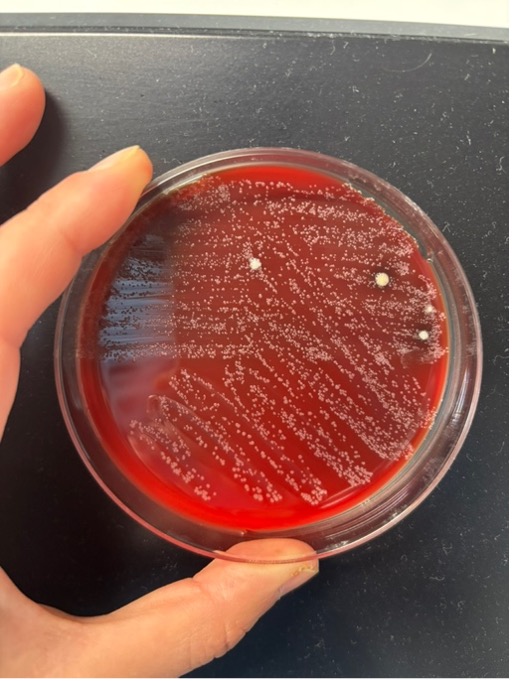
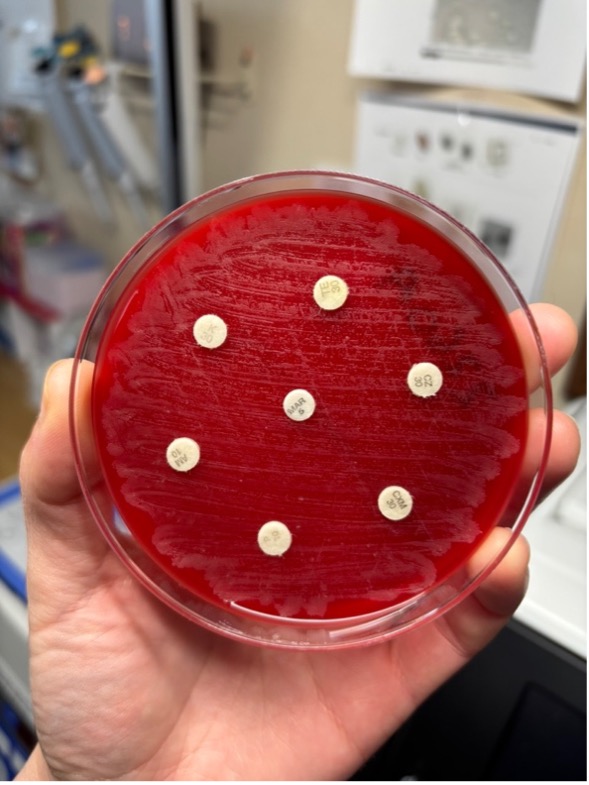
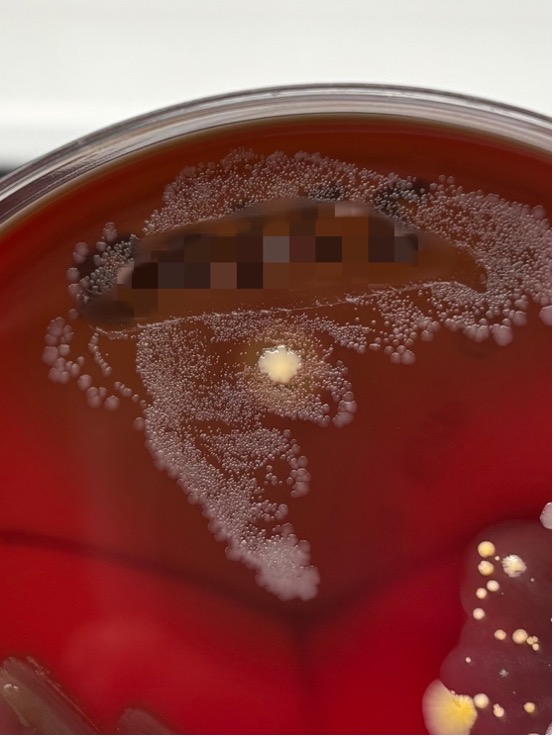

獣医師の渡邉佳和子です。
今回は、いたって教科書レベルの話題ではありますが、Prototheca zopfiiを原因とする牛の乳房炎について詳しく勉強してみようと思います。
Prototheca zopfiiとは
>概要
Prototheca(プロトセカ派とプロトテカ派が存在します。筆者はプロトセカ派です)は、藻類の一種です。
※藻類=酸素発生型光合成を行う生物のうち、主に地上に自生するコケ植物・シダ植物・種子植物を除いたもの。いわゆる「藻(も)」。海藻もこれに含まれます。

ただし葉緑体が退化しており光合成を行わないため、自らエネルギーを作り出すことはできず、従属栄養生物として外部から腐生性または寄生性に栄養を得ています。
「非光合成藻類」「無色藻類」「藻類もどき」などと呼ばれているようです。
環境中(土壌、植物上面、湖沼、汚水中など)または動物の消化管内などに生息しており、ヒトにも動物にも感染する人獣共通病原体です。
>生活環

Protothecaは図のように、母細胞の内部分裂により複数の娘細胞が発生し、やがて母細胞の細胞壁が破れることで娘細胞が新たに放出されます。
以下は実際の感染乳汁から分離されたProtothecaをグラム染色したものです。

破れた母細胞壁は、パックマンのような形に見えるのが特徴です。

>遺伝子型について
Protothecaのうち、牛のプロトセカ乳房炎の主な原因藻種であるP.zopfiiは、少なくとも2つの遺伝子型=genotype1と2に分類されます。
genotype1は自然環境中(湖沼・汚水・土壌・植物の表面など)から主に分類される一方で、欧米および日本のプロトセカ乳房炎から分離された株のほとんどがgenotype2と同定されているようです。
乳房炎の感染経路を特定するために牛舎で行われた調査では、感染牛乳汁のほかにgenotype2が検出されたのは、「牛糞」「牛糞に汚染されたと考えられる牛舎の床、ウォーターカップ」からだったそうです。
今までプロトセカ乳房炎は緑膿菌のように”湿った不衛生な環境が感染の前提にある”と勘違いしていたのですが、実際は「湿潤な環境などに存在するプロトセカ=genotype1」と「乳汁から分離され、かつ牛舎環境からも検出されるプロトセカ=genotype2」は別物で、イメージとしては大腸菌性乳房炎のような感染様式が近いことがわかりました。

どんな乳房炎?
一言で言うと、「難治性かつ牛舎内で感染が広がりやすい厄介な乳房炎」です。
>難治性について
Protothecaは細菌ではないため基本的に抗生剤の効き目はあまり期待できません。
感受性報告があるのは
①カナマイシン
②ゲンタマイシン、加えて抗真菌薬の
③アムホテリシン-B
④イトラコナゾール です。
既出の報告によると、いずれにおいてもgenotype2(乳房炎の原因)はgenotype1よりも薬剤感受性が低く、特にイトラコナゾールに対しては感受性が認められなかったとのことです。
なお、genotype2は塩酸アルキルジアミノエチルグリシン、クロルヘキシジン、次亜塩素酸、ポピドンヨードに対して感受性(殺藻効果)が確認されているため、治療方法として動物用イソジン液の活用も期待できます。
除藻剤による治療が試みられたこともあるそうですが、いずれにせよ明確な効果を示す治療法はなく、早期診断・隔離・淘汰や盲乳処置が推奨されることが多いようです。
>感染力について
プロトセカ乳房炎では、
・乳汁中に病原体が排出される
・感染の有無に関わらず糞便中に病原体が存在する
という2つの要素を併せ持つことから、搾乳器具や搾乳者を介した伝染性の感染も、糞便を介した環境性の感染もどちらも成立します。

また、症状の乏しい潜在性乳房炎にとどまる例も多いことから、気づかないうちに感染牛がどんどん増えているとという事態も想定されるため、感染牛が1頭でも確認されたら他の牛に対しても注意深く検査などを行う必要があります。
>症状
分娩後30日以内の発症が多いと言われています。また、複数乳房での罹患も多いようです。
微熱、乳房の腫脹・硬結・熱感などが見られることもありますが、食欲の減退や心拍・呼吸数の異常は見られません。慢性化した乳房炎では特に治療効果が期待できないそうです。
長期的な抗生剤の使用が後のプロトセカ乳房炎の要因となるとも言われています。
実際の乳房炎
>病原体のすがた
38℃で2晩培養後、コロニーが生えました。白色微小円形で、表面が乾いた感じに見えるのが特徴的です。


×400、×1000の鏡検像。
グラム陽性に染まった大小不同楕円形の娘細胞と、周囲に薄い青色で散見される母細胞の細胞壁が見られるのが特徴的です。
×400では酵母様真菌と間違えてしまいそうなよく似た像が見られるので、注意が必要です。
抗生剤の感受性試験結果。残念ながらどの抗生剤(PC、AMP、KM、TE、CEZ、CXM、MAR)にも感受性を示しませんでした。
上のコロニーが生えた3日後、「同じ牛の別分房も乳房炎」との稟告を受け検査したところ、同様に48時間培養でプロトセカが検出されました。
こちらも感受性試験でどの抗生剤にも感受性を示しませんでした。
>牛の様子

普段通り過ごしており、餌もよく食べています。

左側が罹患分房ですが、右側と比べてひどく腫れている様子はありませんでした。
>治療内容
2分房とも抗生剤投与の効果は見込めないため、イソジン入り生理食塩水の注入を行ったのち、妊娠がわかっている牛のため罹患分房のみ乾乳とすることになりました。

前搾りをすると、カニューラ挿入後の乳汁排出がスムーズになります。
バケツの底に細かいブツが見えます。


イソジンが乳房内で薄まらないように、できるだけ乳汁を排出させます。

いざ注入
終わったらディッピングも忘れずに行います。

プロトセカ乳房炎では重篤な症状が見られることは少ないものの、抗生剤が効きにくく、複数分房で罹患しやすいということも実際の症例からよくわかりました。
これ以上感染が広がらないことを願います!
今回の内容は以上となります。
お読みくださりありがとうございました!


コメント